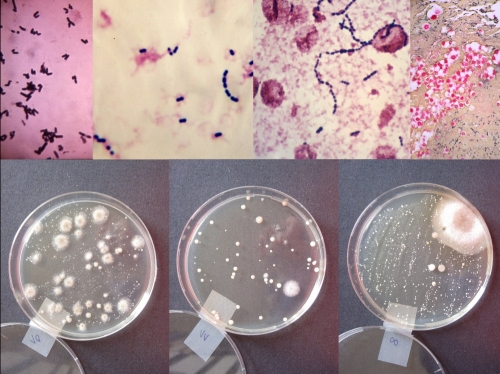

| javne predstavitve projektov, realizacije, sodelovanja na razstavah, festivalih / public presentations of the projects, realizations, participations at the shows, festivals |
 .jpg)        |
| 2013 The Pleasure is Mine. Curator: Vladimir Vidmar, Galerija Škuc, Ljubljana. Project Monologues. |
| 2012 Managing Life, LABTP: Life Art Biopolitics Theory Practice, art director: Nikola Janović, Beograd. Cancelled. |
| 2012 ASYMMETRIC EUROPE, Muzej savremene umetnosti Vojvodine, Novi Sad, 16. 11.-2. 12. 2012. Project Hair. |
| 2012 ARSCOPE,
19.-20. 12. 2012, KHM, Köln |
| 2012 Soft Control: Art, Science, and Technologically Unconscious, curator: Dmitry Bulatov, Maribor: European Capital of Culture. Project Initiation. |
| 2012 Sin origen / Sin semilla, ARTEMASCIENCIA, art director: Maria Antonia Goznalez Valerio, Mexico City. Project Rhizome Nomad. |
2012 Life Affairs / Aféry života,
BIOART show,
18. 10. 2012-18. 11. 2012.
DIG gallery / Strojárenská 3, Košice, Slovakia.  link me here link me here |
| 2012 Sculpture Today. Transhumanism and New Renaissance. Curators:
Tomaž Brejc, Jiri Kočica, Irena Čerčnik, Polona Tratnik. Galerija sodobnih umetnosti Celje / Gallery of Contemporary Art Celje. Project Rhizome Nomad. |
| 2012 Nano Art, curator: Jože Slaček, Maribor: European Capital of Culture. Project Hair - virtual reality edition. |
|
panel discussion with Miško Šuvaković, Miomir Knežević, Mojca Puncer and Ajda Marič. Horizonti in Kapelica Gallery.  link me here link me here |
| 2011 SZENARIEN ÜBER EUROPA.
SZENARIO 1, 10.09.-13.11.2011, GALERIE FÜR
ZEITGENÖSSISCHE
KUNST LEIPZIG, curator: Miško Šuvaković et al. |
| 2011 Kiparstvo danes: Kipi, figure in telesa (Sculpture Today: Sculpture, Figures, Bodies), co-curator, Galerija sodobnih umetnosti Celje (Gallery of Contemporary Art Celje), various locations, 22. 9. – 13. 11. 2011. |
| 2011
BIO+FICTION: Synthetic Biology Science, Art, and Film Festiva, Vienna, 13.-14.5. 2011. |
| 2010 Hair in Vitro, Horizonti, performative intervention June 17, SCCA, Ljubljana. |
| 2010 SEAFAir, The Apparatus of Life and Death, Skopje, October 2010. |
| 2010 Hair In Vitro, Horizonti, performative installation at Kiparstvo danes (Sculpture Today), Galerija sodobnih umetnosti Celje (Gallery of Contemporary Art Celje), 10. 9.–10. 10. 2010. |
| 2010 Kiparstvo danes: Komponente, stičišča in presečišča (Sculpture Today: Components, Links, Intersections), co-curator, Galerija sodobnih umetnosti Celje (Gallery of Contemporary Art Celje), various locations, 10. 9.–10. 10. 2010. |
| 2009 Ecology of Techno Mind, Kapelica Gallery Featured Art Scene, curator Jurij Krpan, Cosinus, European Commission for Science and Research, Berlaymont, Brusseles (Belgium), 30 June 30 September / Unique |
2008 In Vitro & Transspecies, with dr. Miomir Knežević, Kapelica Gallery, Ljubljana (Slovenia), December  link me here for an interview SLO / solo link me here for an interview SLO / solo |
2008 Accidentes Controlades, Ex Teresa Arte Actual, curator Edith Medina, Mexico City (Mexico), November,  link me here / Unique link me here / Unique |
2008 Ars Electronica Festival (A New Cultural Economy), Ecology of Techno Mind, Kapelica Gallery Featured Art Scene, curator Jurij Krpan, Lentos Museum, Linz (Austria), September  link me here and here / Micro Flesh, Unique link me here and here / Micro Flesh, Unique |
2008 Micro Flesh, Cosinus, European Commission for Science and Research, Berlaymont, Brusseles (Belgium), 2 april30 June  link me here and here for the photos / solo link me here and here for the photos / solo |
2007 Land[e]scape. Zeitgenössische Kunst aus Slowenien, curators Breda Kolar Sluga, Simona Vidmar, Künstlerhaus Graz (Austria), JulySeptember  link me here / In-Time link me here / In-Time |
2007 Vit<a>rti, curator Martin uit den Bogaard, Verbeke Foundation, Kemzeke (Antwerpen, Belgium), JuneOctober  link me here / Hair link me here / Hair |
2007 BIOS 4, curator Antonio Cerveira Pinto, Sevilla (Spain)  link me here / Private Bowls link me here / Private Bowls |
2006 Triennial of Contemporary Slovenian Art U3, curator Jurij Krpan, Museum for Modern Art Ljubljana, December 06-January 07  link me here and here and here / Unique link me here and here and here / Unique |
2006 Microcosm, City Gallery Villach (Austria), 14 September18 October  link me here and here: mobuzztv / solo link me here and here: mobuzztv / solo |
2006 Picke = Pussy, curator Nevenka ivavec, Gallery Racka (Likovni salon Celje), Celje (Slovenia), September  link me here / Monologues 02/06 link me here / Monologues 02/06 |
2006 In Vivo in Vitro, curator Anna Hatztigiannakis, Artopos, Academy for Fine Arts, Athens (Greece), 9. 2.12. 3. 2006  link me here and here for the press response and here for the interview GR / Unique link me here and here for the press response and here for the interview GR / Unique |
| 2005 Lasje = Hair, Miklova hia Gallery, Ribnica (Slovenia), October / solo |
2005 Cisto umazano = Pretty - Dirty, kuc Gallery, Ljubljana, Slovenia  link me here / In-Time link me here / In-Time |
2005 Festival BREAK 2.3, various locations: former Intestinal Factory, Botanical Garden, Kodeljevo Castle, Kapelica Gallery, November  link me here / art director link me here / art director |
2005 Festival Touch me, Zagreb (Croatia)  link me here / In(threat)timity, in situ installation link me here / In(threat)timity, in situ installation |
2005 Zeleno, ki te ljubim zeleno = Green as I Love You Greenly, Artreflect, Kodeljevo Castle  link me here / painting exhibition of various authors, curator link me here / painting exhibition of various authors, curator |
| 2005 Lasje = Hair, Mala Gallery (Museum of Modern Art), Ljubljana (Slovenia), May / solo |
2005 95'05: teritoriji, identitete, mreže: slovenska umetnost 1995-2005 = Territories, Identities, Nets: Slovene art 1995-2005, curators Igor Zabel, Igor Španjol, Museum for Modern Art Ljubljana  link me here and here / 37°C link me here and here / 37°C |
| 2004 Zasebne skodelice = Private bowls, Prirodoslovni muzej Slovenije, Ljubljana, December / solo |
2004 Breakthrough, curators Bojana Kunst, Nataša Petrešin, Grote Kerk, Den Haag (Netherlands)  link me here / Private Bowls link me here / Private Bowls |
2004 Sedem grehov = The Seven Sins; Ljubljana Moscow, curators Zdenka Badovinac ZViktor Misiano, Igor Zabel, Museum for Modern Art Ljubljana (Slovenia)  link me here and here link me here and here |
2004 Biennial for Electronic Arts Perth (BEAP), Bio Difference, curators Oron Catz, Ionat Zurr, Perth (Australia)  link me here / Private Bowls link me here / Private Bowls |
2004 Mikrokozmos = Microcosm, City Gallery Nova Gorica (Slovenia), May  link me here and here for the artist's presentation and here:
mobuzztv / solo link me here and here for the artist's presentation and here:
mobuzztv / solo |
| 2004 Osem = Eight, Finžgarjeva gallery, Ljubljana (Slovenia) |
2003 L 'Art Biotech, curator Jens Hauser, Le Lieu Unique, Nantes (France)  link me here and here / 37°C, cold version link me here and here / 37°C, cold version |
2002 Zrcala = Mirrors, curator Petja Grafenauer, Repanšek Gallery, Radomlje (Slovenia)  link me here / in situ installation link me here / in situ installation |
| 2002 Klorofil = Chlorophyll, Bežigrajska galerija, Ljubljana / solo, installation, mixed media |
2002 Med telesnim, City Gallery Slovenj Gradec (Slovenia)  link me here / Monologues link me here / Monologues |
| 2001 37°C, 1st, warm version, Kapelica Gallery, Ljubljana (Slovenia) / solo, installation |
| 2002 EigenArt, Chemnitz (Germany) / installation |
| 2002 nominees for the Vordemberge-Gildewart prize, City Gallery Ljubljana (Slovenia) / mixed media |
| 2001 S2, curator Nadja Zgonik, Miklova hia, Ribnica (Slovenia) / installations |
| 2001 Majski salon = May Saloon, Jakopiceva galerija, Ljubljana / Chairs (donation to Galerija Božidarja Jakca, Kostanjevica na Krki), sculpture |
| 2001 Raznoterost in enost = Variety and and Singularity, curator Emerik Bernard, galerija Murska Sobota / paintings |
| 2001 Fotografija leta 2001, ožji izbor M'zin, Cankarjev dom, Ljubljana / photography |
| 2000 Panoramika, galerija P74, Ljubljana entvid / solo, installation |
| 2000 Break 21, Rog, old factory place, Ljubljana / installation |
| 2000 Nova slovenska umetnost = New Slovenian Art, National Gallery Vaclavske Namesty (Hradcany), Prague (CZ) / paintings |
| 2000 Generation 95, Congress of the European Regional Televisions CIRCOM, Potsdam (Germany) / paintings |
| 2000 Slike = Paintings, galerija tekl, Gornji grad / solo, paintings |
| 2000 Photography of the 2000, final selection, M'zin, Cankarjev dom, Ljubljana / photography |
| 1999 Youth Center Gallery, Velenje / solo, paintings |
| 1999 Kompas Gallery, Ljubljana / solo, paintings |
| 1999 the week of culture in Celje city, various public institutions / installation |
| 1999 Student's Works on Paper, Kudos Gallery, Sidney (Australia) / drawings |
| 1999 Ilirija Gallery, Ljubljana / paintings |
| 1999 Velenje Library / paintings |
| 1999 Tri = Three, Kralj Gallery, Novo Mesto / paintings |
| 1999 Moja Jablana = My Apple Tree, curators Harald Draušbaher, Tone Kuntner, City Theatre Ljubljana / illustrations |
| 1999 Isto ni isto = Same is not the Same, curator Emerik Bernard, Miklova hia, Ribnica / paintings |
| 1999 Ekologija = Ecology, Biotechnical Faculty / installation |
| 1999 Prostori onkraj hitrosti in hrupa = Spaces Beyond Speed and Noise, Zimski salon / Winter Sallon, curator Dominik Križan, City Gallery Ljubljana / video work |
| 1999 Razkrivajoca navzocnost telesa = Disclosing Presence of Body, curators Franc Novinc, Emerik Bernard, City Gallery Ljubljana / drawings |
| 1998 25. Salon mladih = 25th Saloon of Youth, Zagreb (Croatia) / video work |
| 1998 Festival of Computer Art, Maribor (Slovenia) / video work |
| 1998 Razkrivajoca navzocnost telesa = Disclosing Presence of Body, curators Franc Novinc, Emerik Bernard, Miklova hia, Ribnica (Slovenia) / drawings |
| |
|

.jpg)